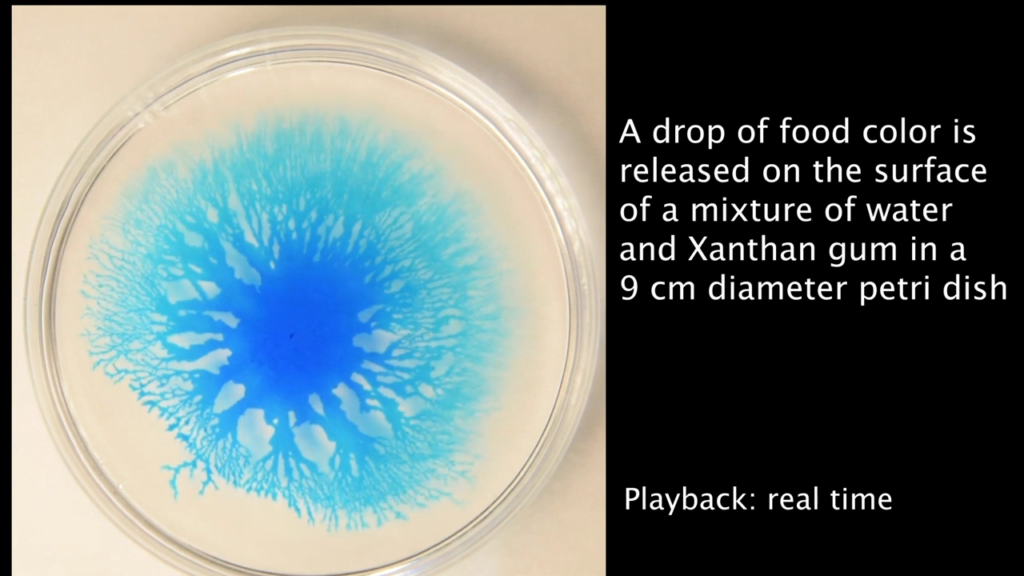
A drop of food coloring released onto a petri dish filled with a mixture of water and xanthan gum spreads in a fractal pattern. A drop of food coloring released onto a petri dish filled with a mixture of water and xanthan gum spreads in a fractal pattern.

With the right balance of viscosity and surface tension, many fluid combinations can form fractal or dendritic patterns. Here, researchers use a drop of food coloring atop a mixture of water and xanthan gum. Depending on the concentration of gum (and the age of the viscous fluid) different fractal patterns spread quickly across the surface. (Image and video credit: R. Camassa et al.)
Fast Fractal Fingers

Comments
One response to “Fast Fractal Fingers”

This looks very similar to a pottery decorating technique called mocha diffusion. A mild acid is mixed with a colourant then dripped/spattered onto clay slip on the surface of a pot. Because the clay is basic, the acid diffuses outwards in a very similar way to this, and draws the colourant with it. Then the pot is dried. It’s often used to make an effective impression of trees in winter.

Leave a Reply